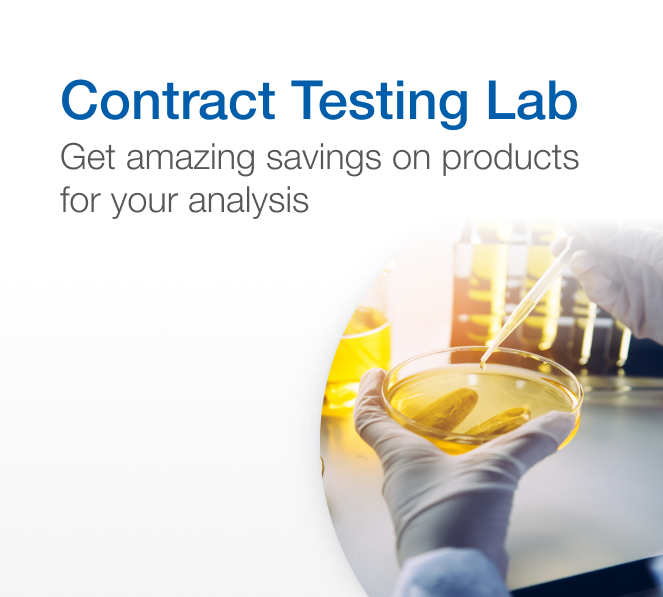

Contract Testing Lab
Enhance Your Contract Testing Lab with Precision Solutions
Discover our premium selection for contract testing labs! We provide cutting-edge biologicals, high-purity chemical reagents, and state-of-the-art equipment designed to ensure the accuracy, reliability, and reproducibility of your results. Elevate your analysis with our top-tier solutions and maintain the highest standards of scientific integrity and credibility.
Enter promotion code 24138 at checkout to unlock up to 60% off your purchase. Take advantage of our exceptional selection and unbeatable prices before 30 April 2025*.
Find your products in the categories shown below or browse through the all-products list beneath.
- Filtration
- Glassware
- Other Plasticware
- Pipette Tips
- Pipetters and Dispensers
- Plastic Bottles
Glass, Plastic, and Liquid Handling
- Chromatography Consumables
Chromatography
- Lab Supplies
Lab Consumables
- Blenders and Homogenizer
- Constant Temperature
- Hotplates and Stirrers
- Vortex Mixers
- Washers and Dryers for Glassware and Accessories
Lab Appliances
- Life Science Instruments
- Microbiology